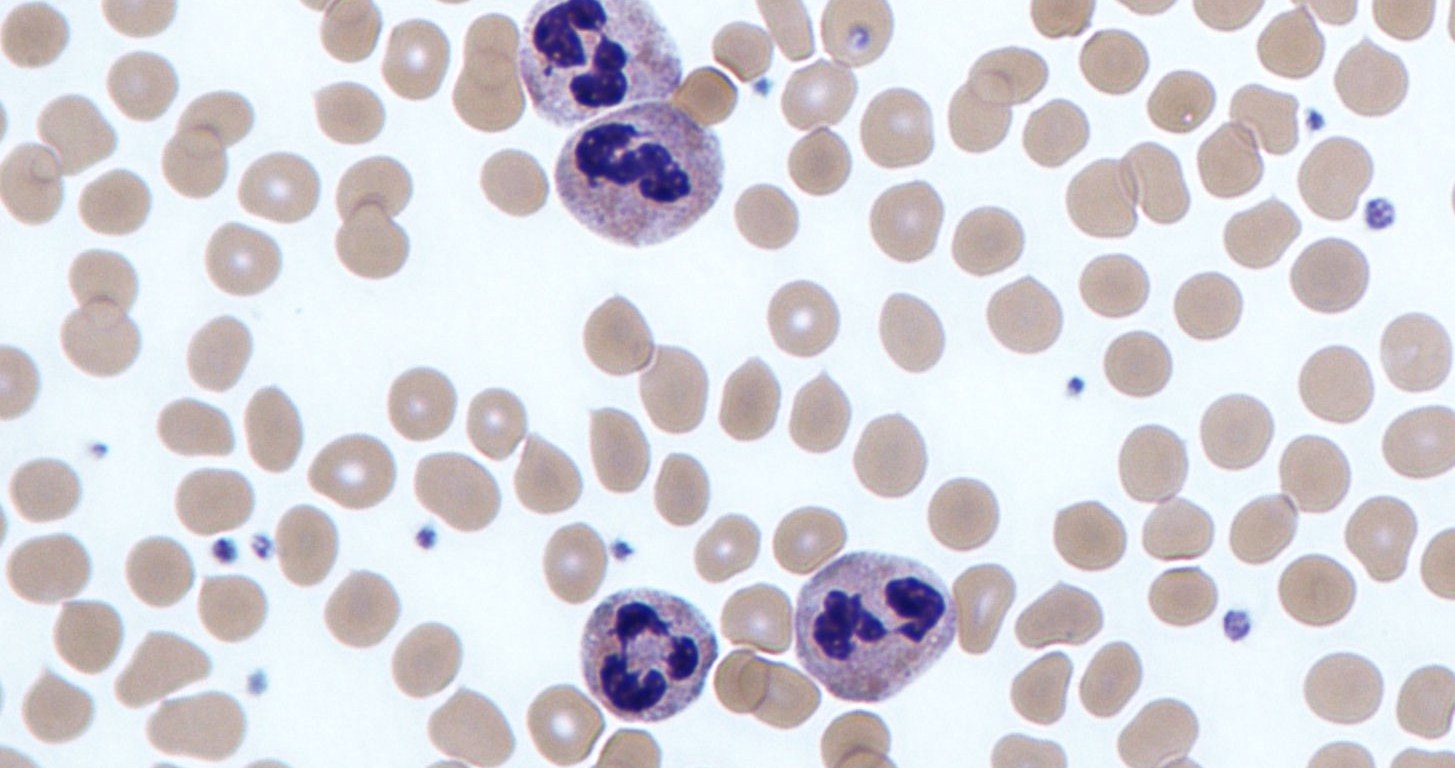

by Richard Liang ’18
The term “cancer” comprises various diseases involving abnormal cell growth. They become most dangerous after metastasis, when they spread to multiple organs. Though few treatments are currently available for cancers past this stage, a recent study led by Dr. Juwon Park in Cold Spring Harbor Laboratory has identified neutrophils, a type of leukocyte in the blood, as a potential therapeutic target for preventing metastasis.
This experiment involved monitoring neutrophil levels in breast cancer cells. Tumors were induced by transplanting cancerous cells into the breasts of mice. The lab mice were then divided into two groups: mice who had undergone 4T1 murine breast cancer cells transplants and mice who had undergone 4T07 murine transplants. The 4T1 cells were more prone to metastasize than the 4T07 cells. Confocal intravital lung imaging (CILI) was used to investigate the presence of any abnormal structures involved in the relationship between neutrophils and the onset of metastasis, especially any colocalized DNA structures.
The results demonstrated neutrophil levels in the 4T1 mice that were almost five times higher than those in the 4T07 mice. CILI results indicated that neutrophils developed neutrophil extracellular traps (NETs) which promoted cancer metastasis. It was suggested that the rise in neutrophil levels was linked to the onset of metastasis. Based on this discovery, researchers are now trying to target neutrophils and the NETs to develop potential methods for preventing cancer metastasis.
References:
- J. Park, et al., Cancer cells induce metastasis-supporting neutrophil extracellular DNA traps. Science Translational Medicine (2016).
- Image retrieved from: https://upload.wikimedia.org/wikipedia/commons/0/09/Neutrophils.jpg

